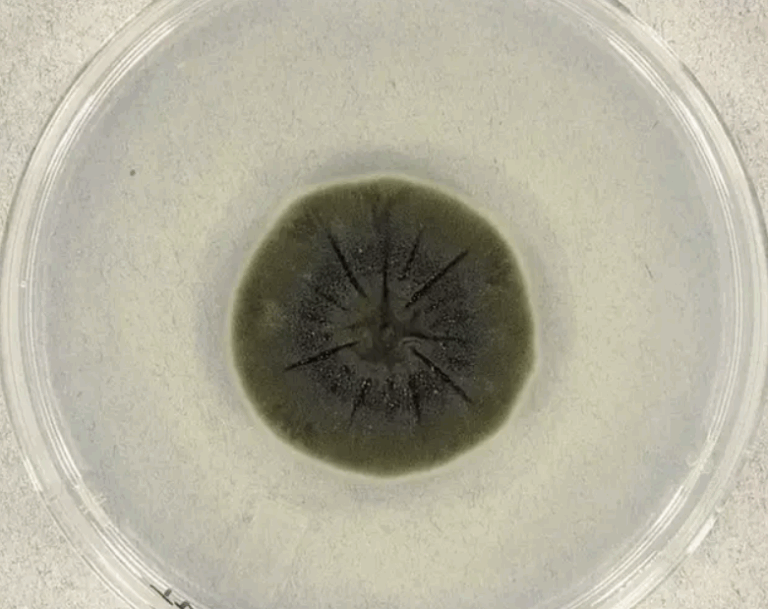

Αρχές στη Σκανδιναβία ανέφεραν πως εντόπισαν ελαφρώς αυξημένα επίπεδα ραδιενέργειας στη βόρεια Ευρώπη αυτόν τον μήνα, για τα οποία Ολλανδοί αξιωματούχοι αναφέρουν πως ίσως οφείλονται σε κάποια πηγή στη δυτική Ρωσία και μπορεί να «υποδεικνύουν ζημιά σε κάποιοι στοιχείο καυσίμων σε κάποιον σταθμό πυρηνικής ενέργειας».
Ωστόσο το ρωσικό ειδησεογραφικό πρακτορείο TASS, επικαλούμενο εκπρόσωπο της κρατικής Rosenergoatom, μετέδωσε πως οι δύο πυρηνικές εγκαταστάσεις στη βορειοδυτική Ρωσία δεν έχουν αναφέρει προβλήματα.
Ο σταθμός Λένινγκραντ κοντά στην Αγία Πετρόπουλη και ο σταθμός Κόλα κοντά στο Μουρμάνσκ «λειτουργούν κανονικά, με τα επίπεδα ραδιενέργειας να είναι εντός κανονικών πλαισίων» μετέδωσε το Tass.
Οι αρμόδιες φινλανδικές, νορβηγικές και σουηδικές αρχές ανέφεραν πως εντόπισαν μικρές ποσότητες ραδιενεργών ισοτόπων αβλαβών για τους ανθρώπους και το περιβάλλον σε τμήματα της Φινλανδίας, της βόρειας Σκανδιναβίας και της Αρκτικής.
22 /23 June 2020, RN #IMS station SEP63 #Sweden🇸🇪 detected 3isotopes; Cs-134, Cs-137 & Ru-103 associated w/Nuclear fission @ higher[ ] than usual levels (but not harmful for human health). The possible source region in the 72h preceding detection is shown in orange on the map. pic.twitter.com/ZeGsJa21TN
— Lassina Zerbo (@SinaZerbo) June 26, 2020
Η Σουηδική Αρχή Ασφαλείας Ραδιενέργειας ανέφερε την προηγούμενη Τρίτη πως «δεν είναι δυνατόν να επιβεβαιώσουμε ποια θα ήταν η πηγή των αυξημένων επιπέδων» ή από πού μπορεί να έφτασε ένα νέφος με ραδιενεργά ισότοπα που φέρεται να πετά πάνω από τη βόρεια Ευρώπη. Οι αρχές της Φινλανδία και της Νορβηγίας δεν προέβησαν σε εικασίες για μια πιθανή πηγή.
Ωστόσο το Εθνικό Ινστιτούτου Δημόσιας Υγείας και Περιβάλλοντος στην Ολλανδία ανέφερε την Παρασκευή πως ανέλυε τα σκανδιναβικά δεδομένα και «αυτοί οι υπολογισμοί δείχνουν πως τα ραδιονουκλεΐδια προέρχονται από την κατεύθυνση της δυτικής Ρωσίας».
«Τα ραδιονουκλεΐδια είναι τεχνητά, οπότε αυτό σημαίνει πως δημιουργήθηκαν από ανθρώπους. Η σύνδεσή τους μπορεί να υποδεικνύει ζημιά σε στοιχείο καυσίμου μιας πυρηνικής εγκατάστασης» ανέφερε η ολλανδική υπηρεσία, τονίζοντας ωστόσο πως δεν μπορεί να επιβεβαιωθεί συγκεκριμένη πηγή.
Σύμφωνα με τον επικεφαλής του CTBTO (Comprehensive Nuclear-Test-Ban Treaty Organization), τα σωματίδια ( Cs-134, Cs-137 & Ru-103) εντοπίστηκαν στις 22- 23 Ιουνίου.
Η ΙΑΕΑ – η αρμόδια υπηρεσία του ΟΗΕ- ανέφερε το Σάββατο πως έχει ενημερωθεί και ότι αναμένει πιο πολλές πληροφορίες από κράτη- μέλη.